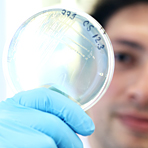

Klinikkeime: Toleranz gegen Desinfektionsmittel möglich |
Bakterien können offenbar nicht nur resistent gegen Antibiotika, sondern auch gegen Antiseptika werden. Das zeigt eine aktuelle Untersuchung aus Australien, die Dr. Sacha Pidot und seine Kollegen von der Universität Melbourne nun im Fachjournal «Science Translational Medicine» veröffentlicht haben. Demnach wird der multiresistente Darmkeim Enterococcus faecium in Krankenhäusern zunehmend tolerant gegen alkoholbasierte Desinfektionsmittel. Dies könne die Zunahme von nosokomialen Infektionen mit dem Erreger erklären.
Antibiotika-resistente Erreger wie der multiresistente Staphylococcus aureus (MRSA) bereiten Kliniken schon seit Jahrzehnten zunehmend Probleme. Deshalb wurden strikte Hygienemaßnahmen eingeführt wie regelmäßige Händedesinfektion bei den Mitarbeitern und auch Desinfektion der Räume. Trotzdem ist die Zahl der Infektionen mit gegen verschiedene Antibiotika resistenten Enterococcus faecium angestiegen.
Daher untersuchten Pidot und seine Kollegen genauer, wie empfindlich die Erreger auf alkoholbasierte Desinfektionsmitteln reagieren. Hierfür arbeiteten sie mit 139 Proben von Enterococcus faecium, die zwischen 1997 und 2015 in zwei Kliniken in Melbourne genommen worden waren. Die Erreger aus diesen Proben setzten die Forscher verdünntem Isopropanol (23 Prozent) aus. Die nach 2009 gewonnen Isolate vertrugen den Alkohol deutlich besser als die vor 2004 gewonnenen Bakterien.
Da der optimale Wirkbereich von Isopropanol zwischen 60 und 85 Prozent liegt und die meisten Antiseptika den Alkohol in einer Konzentration von mindestens 70 Prozent enthalten, sind diese Ergebnisse zunächst nicht wirklich aussagekräftig. Um die klinische Relevanz der Ergebnisse zu testen, unternahmen die Forscher daher einen zweiten Versuch: Sie kontaminierten die Böden von Mäusekäfigen mit verschiedenen Enterococcus-faecium-Stämmen. Dann reinigten sie die Böden mit Desinfektionstüchern, die mit 70-prozentigem Isopropanol imprägniert waren. Anschließend setzten sie Mäuse in die Käfige und analysierten nach einer Woche, welche Bakterienstämme im Darm der Tiere zu finden waren.
Dabei zeigte sich, dass die Stämme, die in dem Killing-Assay zuvor als alkoholtolerant identifiziert worden waren, deutlich besser die Mäuse kolonisieren konnten als die alkoholsensiblen. Eine Genomanalyse zeigte, dass die alkoholtoleranten Bakterien eine Reihe von Mutationen in Stoffwechsel-Genen aufwiesen, die die Alkoholtoleranz bedingen. Die Forscher betonen, dass nur Daten aus zwei Krankenhäusern in Melbourne untersucht wurden, ob und in welchem Ausmaß Resistenzen gegen Desinfektionsmittel auch in anderen Regionen beziehungsweise Ländern vorkommen, müsse noch geprüft werden. (ch)
DOI: 10.1126/scitranslmed.aar6115
08.08.2018 l PZ
Foto: Universität Kiel/Christian Urban (Symbolfoto)